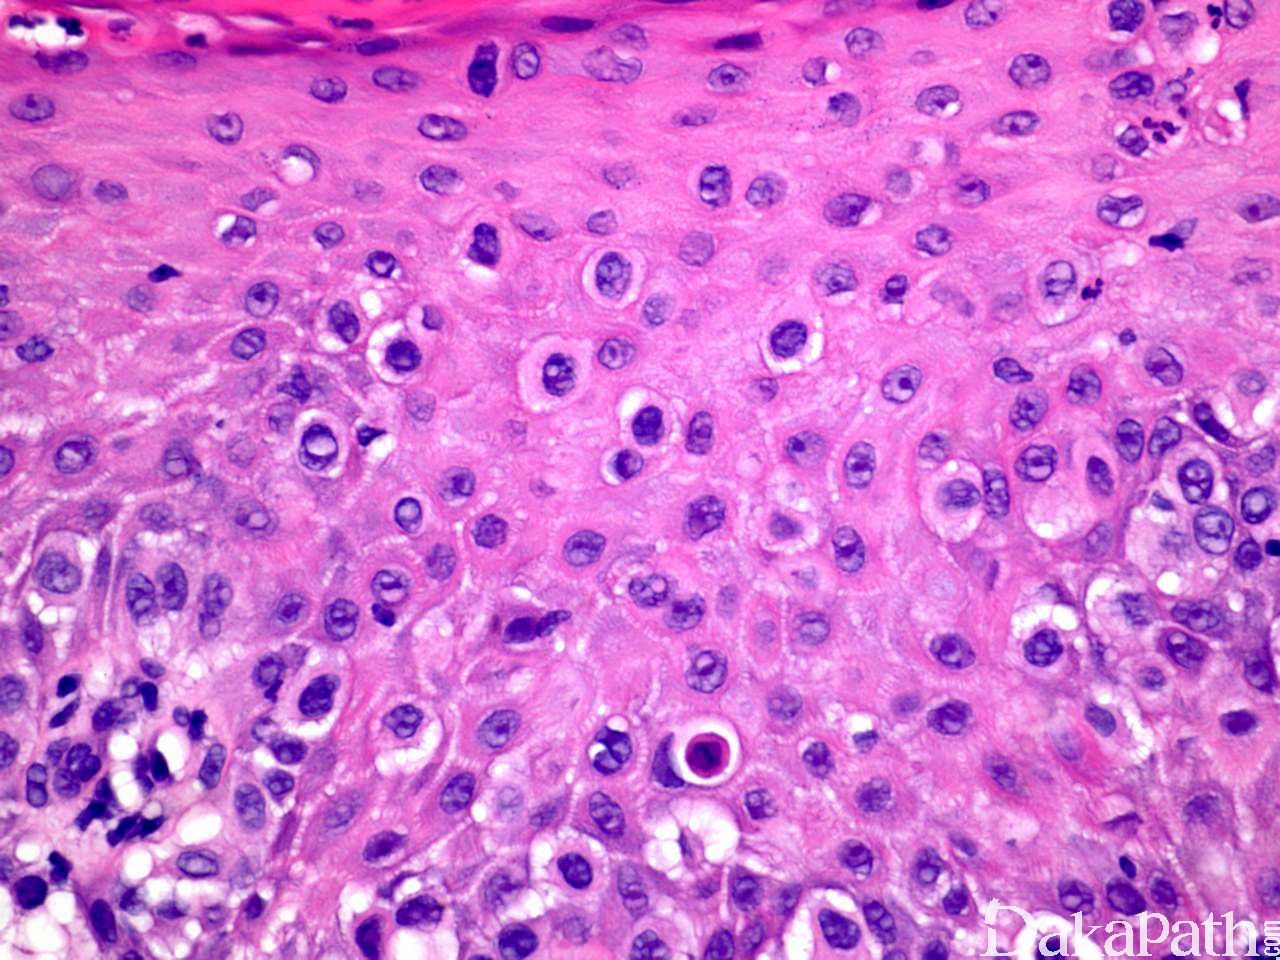

乳腺外 Paget 病
Extra Mammary Paget Disease
概述:
Paget 病一般定义为表皮内的腺癌,在乳腺以外部位可能代表着原发性汗腺癌
发病部位: 生殖器和会阴区、腋窝、眼睑
诊断要点:
主要发生在老年人,最常见的部位是肛门生殖器区,其次是腋窝,表现为界限不清的湿疹样红色斑块,伴瘙痒;
组织学特征性地表现为表皮内非典型上皮细胞单个散在或成群分布于上皮各层内,有时可形成导管或腺样结构;
细胞体积大,胞质淡染、内含黏液或透亮,有时可伴有黑色素颗粒;
Paget 细胞间常见裂隙样结构;
表皮可显著增生。

免疫组织化学染色:
原发性 ENPD 呈 CEA、CK7. CAM5.2. EMA/MUC1. GCDFP-15 及 BER-EP4 阳性,而黑色素标记阴性;与尿路上皮癌相关的继发性 EMPD 呈 uroplakin-2/-3. GATA3. CK7 及 CK20 阳性;与肛门/直肠癌相关的继发性 EMPD 呈 CK20. CDX-2 及 CEA 阳性。
鉴别诊断:
鳞状细胞原位癌 (Bowen 病):除大细胞外,其它细胞也有异型,Cam5.2 通常阴性。
黑色素瘤:Mart-1. Melan-A 或酪氨酸酶免疫组化染色阳性。
